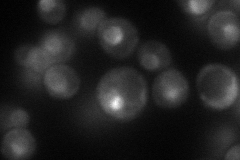
YPL210C
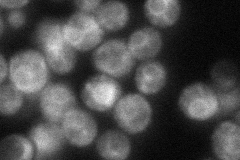
YPL210C
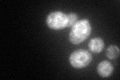
YPL210C
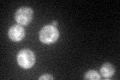
YPL210C

View description
Core component of the signal recognition particle (SRP) ribonucleoprotein (RNP) complex that functions in targeting nascent secretory proteins to the endoplasmic reticulum (ER) membrane
Localization:
Intensity:
Fold change:
Significance:
-
C’ GFP library in SD

ER73.63 -
N' NOP1pr-GFP in SD
nuclear periphery71.3729 -
N' TEF2pr-mCherry in SD

nucleolus12.3736 -
N' NATIVEpr-GFP in SD
ER63.2748 -
N' TEF2pr-VC and Cyto-VN in SD

cytosol27.2198 -
C’ GFP library in SD+DTT
ER70.990.96No -
C’ GFP library in SD+H2O2
ER74.641.01No -
C’ GFP library in Starvation Media

ER40.750.55Yes -
C’ GFP library on the background of Pup2-DaMP

ER -
C’ GFP library on the background of CCT mutant

ER82.31621.11792No
